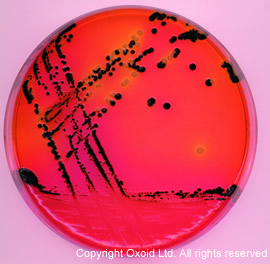
Oxoid CM0469B/CM0469R/CM0469T

相关产品推荐更多 >
万千商家帮你免费找货
0 人在求购买到急需产品
- 详细信息
- 文献和实验
- 技术资料
- 库存:
99
- 英文名:
XLD Medium
- 供应商:
北京云肽生物科技有限公司
英国Oxoid于1924年成立,现属于知名的Thermo Fisher Scientific集团一员,目前为领先全球的微生物培养基制造商与诊断试剂销售商。公司总部位于英国贝星斯托克(Basingstoke),产品销售遍及欧盟各国、美洲与澳洲,另外也委托**各地专业的微生物产品代理商经营国际Oxoid事业。Oxoid产品范围阔及与疾病、微生物诊断相关的临床检验科学、基础学术研究与工业生产领域。英国Oxoid是世界上第二大微生物相关产品的生产商,总部设在英格兰Basingstoke,在全球14个国家设有分公司,并在62个国家和地区设有经授权的代理商。Oxoid培养基、微生物培养、诊断试剂、生化鉴定、药敏纸锭。
我们北京云肽生物科技有限公司作为Oxoid公司的特约经销商为客户提供,保证原装正品,货期稳定,折扣好的服务标准。
Oxoid CM0469B/CM0469R/CM0469T XLD琼脂(干粉)500g,2.5kg,5kg,产品简介:
产品品牌:Oxoid
产品名称:XLD琼脂(干粉)
英文名称:XLD Medium
产品货号:CM0469B/CM0469R/CM0469T
产品规格:500g,2.5kg,5kg
本产品详情页介绍里面出现*或X代表有网络不能使用的词汇,如需详细的说明请联系本店客服。
产品说明:
使用选择性 Thermo Scientific™ Oxoid™ XLD 琼脂(干粉)从临床标本和食品中分离沙门氏菌和志贺氏菌。 本款培养基依赖木糖发酵、*氨酸**反应并产生硫hua氢,主要用于区分非致病*与志贺氏菌和沙门氏菌。精心加入脱氧胆酸钠可抑制大肠菌群生长,但不会降低支持志贺氏菌和沙门氏菌的能力。
沙门氏菌和志贺氏菌是细*性肠道疾病的主要致病*,其通过粪口途径、人际接触、摄入被污染的食品或水得以传播。
使用 XLD 培养基用于筛查含疑似肠道致病*混合菌群的样品,例如医学标本或食品。
- 易于读取:轻松区分沙门氏菌(中心多处为黑色的红色菌落)、志贺氏*(红色菌落)和其他大肠菌群(黄色、不透明菌群)。
- 卓越的灵敏度和选择性:超过了传统平板培养基,例如倾向于抑制志贺氏菌生长的伊红美蓝和***铋琼脂。
XLD培养基(木糖赖氨酸去氧胆酸盐琼脂) CM0469
配方表:
| 成分* | 含量 g/L |
| 酵母粉 | 3.0 |
| L-**盐酸盐 | 5.0 |
| 木糖 | 3.75 |
| 乳糖 | 7.5 |
| 蔗糖 | 7.5 |
| 去氧胆** | 1.0 |
| *化* | 5.0 |
| X代X酸钠 | 6.8 |
| 柠檬X铁铵 | 0.8 |
| **红 | 0.08 |
| 琼脂 | 12.5 |
| pH 7.4±0.2 @25℃ |
制备方法:
添加53g 培养基至1L 蒸馏水中,加热并频繁搅动培养基至其沸腾,不要过度加热,立即转移到50℃水浴中。分装至无菌培养皿待其冷却后使用。
避免一次性制备大量培养基至使加热时间过长。
产品描述:
XLD是Xylose-Lysine-Desoxycholate Agar的简称,中文名称木糖**酸去
技术指导:
粪便或肛门拭子可以直接涂布在XLD平板上,或者可以在涂布之前使用选择性增*肉汤,Selenite Broth CM0395 或者 Tetrathionate Broth CM0029可以用作沙门氏*的增*。
1、从适合的增*肉汤中接种到XLD平板上,或者从粪便样品或肛门拭子上取样涂布到平板上;
2、在35-37℃下培养18-24小时。
典型菌落图
质控:
鼠伤寒sha门氏菌ATCC14028 48h,生长良好,带有黑色中心的红色*落
大肠埃希氏菌ATCC25922 不生长
干粉培养基10-30℃保存,制成培养基2-8℃保存。
Oxoid CM0469B/CM0469R/CM0469T XLD琼脂(干粉)500g,2.5kg,5kg,产品订购信息:
| 货号 | 名称 | 规格 |
| CM0469B | XLD琼脂(干粉)XLD Medium | 500g |
| CM0469R | XLD琼脂(干粉)XLD Medium | 2.5kg |
| CM0469T | XLD琼脂(干粉)XLD Medium | 5kg |

以下是Oxoid品牌部分产品订购信息,如需其他产品请联系本店客服
| 货号 | 名称 | 规格 |
| CM0813K | SORBITOL MACCONKEY AGAR NO3 25 KILOS | 25kg |
| CM0813R | SORBITOL MACCONKEY AGAR 2.5KG | 2.5kg |
| CM0817B | M17 BROTH 500GRAMS | 500g |
| CM0833B | AEROMONAS MED BASE (RYAN) SUPP500GRAMS | 500g |
| CM0839B | GELATINE AGAR 500GRAMS | 500g |
| CM0843B | MRS BROTH (MODIFIED) 500g | 500g |
| CM0853B | E.C. BROTH 500G | 500g |
| CM0854B | SHEEP BLOOD AGAR NO 2 500GRAMS | 500g |
| CM0854T | SHEEP BLOOD AGAR BASE 5KG | 5kg |
| CM0856B | LISTERIA SELECTIVE AGAR BASE 500G. | 500g |
| CM0862B | LISTERIA ENRICHMENT BROTH B. | 500g |
| CM0862T | LISTERIA ENRICHMENT BROTH BASE5KILOS | 5kg |
| CM0863B | LISTERIA ENRICH BROTHBASE UVM 500GRAMS | 500g |
| CM0863R | LISTERIA ENRICHMENT BROTH BASE (UVM) | 2.5kg |
| CM0866B | RAPPAPORT VASSILIADIS SOYA PEP500GRAMS | 500g |
| CM0868B | AZIDE DEXTROSE BROTH (ROTHE) 500GRAMS | 500g |
| CM0877B | PALCAM AGAR BASE 500G. | 500g |
| CM0877R | PALCAM AGAR BASE | 2.5kg |
| CM0881B | STAA AGAR BASE 500G | 500g |
| CM0882B | VIOLET RED BILE AGAR (MODIFIED500GRAMS | 500g |
| CM0888B | BILE AESCULIN AGAR 500GRAMS | 500g |
| CM0895B | FRASER BROTH 500GRAMS | 500g |
| CM0895R | FRASER BROTH | 2.5kg |
| CM0895T | FRASER BROTH 5 KILOS | 5kg |
| CM0897B | BUFFERED LISTERIA ENRICHMENT BR | 500g |
| CM0897R | BUFFERED LISTERIA ENRICHMENT BROTH 2.5K | 2.5kg |
| CM0897T | BUFFERED LISTERIA ENRICHMENT BROTH 5KG | 5kg |
| CM0898B | HAEMOPHILUS TESTING MEDIUM | 500g |
| CM0906B | R2A AGAR 500GRAMS | 500g |
| CM0906R | R2A AGAR | 2.5kg |
| CM0910B | MOD SEMI-SOLID RAP VASS(MSRV)M500GRAMS | 500g |
| CM0919B | MEMBRANE LAURYL SULPHATE AGAR 500GRAMS | 500g |
| CM0920A | YEAST AND MOULD AGAR 100GM | 100g |
| CM0920B | YEAST AND MOULD AGAR 500GRAMS | 500g |
| CM0927B | DIFFERENTIAL REINFORCED CLOST 500GRAMS | 500g |
| CM1185B | MYP AGAR 500GRAMS | 500g |
| CM0931B | LACTOSE PEPTONE BROTH 500GRAMS | 500g |
| CM0931T | LACTOSE PEPTONE BROTH 5KILOS | 5kg |
| CM0933B | KF STREPTOCOCCUS AGAR 500GRAMS | 500g |
| CM0935B | KARMALI AGAR BASE 500GRAMS | 500g |
| CM0944B | TERGITOL 7 BROTH 500G | 500g |
| CM0945A | TBX MEDIUM 100GRAMS | 100g |
| CM0945B | TBX MEDIUM 500GRAMS | 500g |
| CM0945M | TBX AGAR 8kg | 8kg |
| CM0945R | TBX MEDIUM 2.5kg | 2.5kg |
| CM0947T | YEAST PEPTONE AGAR 5KG | 5kg |
| CM0949A | CHROMOGENIC UTI MEDIUM 100G | 100g |
| CM0949C | CHROMOGENIC UTI MEDIUM 400G I | 400g |
| CM0949T | CHROMOGENIC UTI MEDIUM 5KG | 5kg |
| CM0951T | MRS BROTH MODIFIED 5KILOS | 5kg |
| CM0953B | MERCK DERMATOPHYTE SELECTIVE A500GRAMS | 500g |
风险提示:丁香通仅作为第三方平台,为商家信息发布提供平台空间。用户咨询产品时请注意保护个人信息及财产安全,合理判断,谨慎选购商品,商家和用户对交易行为负责。对于医疗器械类产品,请先查证核实企业经营资质和医疗器械产品注册证情况。
 文献和实验
文献和实验primary fibroblasts (˜ cell number 1 x 106 ) use: A. 25 ml rat tail collagen (approx conc 2mg/ml) B. 3 ml 10xMEM C. 0.22 M NaOH: first, add 2ml, then drop-wise whilst stirring, until the collagen turns
;0 =-0.2787V。HRP的辅基和酶蛋白最大吸收光谱分别为403nm和275nm,一般以OD403nm/OD275nm的比值RZ(德文Reinheit Zahl)表示酶的纯度。* ?# p. n2 ~1 w. X3 b 酶标记物包括酶标记抗原 、酶标记抗体和酶标记SPA等。酶标记物质量的好坏直接关系到免疫酶技术的成功与否,因此被称为关键的试剂。酶标记物中最常用的是酶标记抗体,它是将酶与特异性抗体经适当方法连接而成。酶标记抗体的质量主要取决于纯度好、活性强及亲和力高的酶和抗体,其次要有良好
:20.0 g 蒸馏水:1000 ml pH 6.8 145.(Oxoid CM3) Lab-Lemco′beef extract :1 g; 酵母膏 :2 g; 蛋白胨:5 g ; NaCl :5 g; 琼脂 :15 g ; 蒸馏水 :1 000 ml。 pH 7.4 146. 综合PDA琼脂(AS 17) 葡萄糖 :20.0 g; KH2PO4: 3.0 g;
 技术资料
技术资料暂无技术资料 索取技术资料










